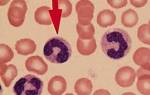

Как правильно сдать анализы
Для обеспечения точности результатов анализов необходимо придерживаться некоторых простых правил:
- У детей и взрослых, анализ берут только натощак, разрешается попить немного воды.
- Если анализ не назначен на утро, желательно поесть за 8 часов до сдачи крови.
- Для получения точных результатов необходимо прекратить прием медикаментов за две недели до проведения исследования. Если это невозможно, следует сообщить об этом лаборанту.
- Накануне сдачи крови, рекомендуется избегать жирной пищи, спиртных напитков и лишних раздражителей.
- За два дня до анализа, стоит вести спокойный образ жизни и отказаться от физических нагрузок.
При соблюдении указанных правил можно быть уверенным, что полученные результаты будут достоверными, что позволит выявить наличие заболевания.
Медицинский специалист рекомендует пройти повторное обследование на мононуклеоз, так как в начальной стадии заболевания симптомы могут проявляться слабо. Поэтому во время острой фазы может потребоваться дополнительное исследование. Если результаты подтверждаются, то врач сможет точно поставить диагноз заболевания.
Когда заболевание прогрессирует у детей, врачи рекомендуют обратиться к гематологу. В течение года после выздоровления, ребенку следует избегать физических нагрузок и отказаться от профилактических прививок.
Симптомы
Дети и подростки более подвержены мононуклеозу, чем взрослые, потому что их организм постоянно растет, и их иммунная система еще не так крепка, как у взрослых.
Период инкубации продолжается около 20-22 дней, что означает, что в течение этого времени не будет явных признаков болезни. Болезнь длится примерно 7-8 недель, и ее основные симптомы проявляются в разные периоды заболевания, что затрудняет диагностику.
Основные признаки мононуклеоза включают повышение температуры тела, что проявляется лихорадкой, а также потливость, усталость, общую слабость, увеличение лимфатических узлов в области шеи, воспаление миндалин и покраснение горла. У детей дошкольного и младшего школьного возраста также могут возникать случаи ангины на фоне инфекционного мононуклеоза. Это заболевание также может спровоцировать осложнения в виде простудных и других вирусных заболеваний, которые могут протекать довольно тяжело из-за ослабленной иммунной системы.
Симптомы инфекционного мононуклеоза у детей и взрослых похожи на проявления многих других вирусных заболеваний, поэтому точный диагноз можно установить лишь после тщательного обследования.
Поскольку очевидные признаки инфекционного мононуклеоза проявляются после периода инкубации, когда начинается поражение всех органов и тканей, особенно важно регулярно проверять детей на наличие инфекционного мононуклеоза.
Другие методы исследования

Общий анализ крови на мононуклеоз у детей и взрослых представляет собой один из наиболее простых и надежных методов первичной и достаточно точной постановки диагноза. Однако в настоящее время существуют и другие методы исследования, которые позволяют подтвердить наличие возбудителя, а именно вируса Эпштейна-Барр, с высокой точностью. Среди них следующие виды лабораторной диагностики:
- Антитела типа Ig М и G, направленные против капсидного антигена вируса Эпштейна-Барр.
Этот анализ иммунологии играет ключевую роль в серологической диагностике инфекционного мононуклеоза. Антитела классов М и G появляются в острой фазе инфекции и обнаруживаются практически у всех пациентов с этим заболеванием, независимо от их возраста. После выздоровления иммуноглобулины класса М постепенно исчезают из крови, в то время как иммуноглобулин G циркулирует в крови на протяжении всей жизни.
Необходимо помнить, что данные полученные при однократном серологическом исследовании имеют ограниченную информативность для установления диагноза. Для полноценной оценки необходимо изучить оба типа иммуноглобулинов, учитывая также клиническую картину и результаты периферического анализа крови.
- определение генетического материала вируса в образце эпителиальных клеток ротоглотки, носоглотки и слюны.
Этот исследовательский проект направлен на выявление генома возбудителя с использованием метода . Известно, что вирус Эпштейна-Барр не только способен вызвать острый мононуклеоз, который проходит бесследно, но также может быть причиной различных новообразований лимфоидных органов и даже способствовать развитию онкологических заболеваний.
Этот анализ полезен не только для пациентов, у которых происходит характерное изменение лимфатических узлов и появление атипичных мононуклеаров в результатах клинических анализов крови, но также для выявления нетипичных форм заболевания или хронического носительства ВЭБ.
Это может быть острая респираторная инфекция с высокой температурой, состояние резкого ослабления защитных сил организма при иммуносупрессивной терапии, поиск причин ОРВИ у ВИЧ-инфицированных пациентов и при выявлении лимфопролиферативных злокачественных опухолей. Тест на определение ДНК вируса является надежным, и результат анализа может быть либо положительным, указывающим на наличие вируса, либо отрицательным. В последнем случае речь может идти как об отсутствии инфекции, так и о низкой концентрации вируса.
Однако, в любом случае, первым методом лабораторной диагностики мононуклеоза является общий анализ крови. Его информативность в сочетании с характерной клинической картиной типичных случаев позволяет точно поставить диагноз лимфоцитарной ангины или инфекционного мононуклеоза как у детей, так и у взрослых пациентов.
Какая требуется диагностика при мононуклеозе
Заразиться мононуклеозом можно в результате заражения лимфокриптовирусом ВГЧ-4, который относится к семейству лимфотропных герпесвирусов. Если у человека ослабленный иммунитет или его недостаток (например, при СПИДе, раке и других заболеваниях), вирус быстро размножается, вызывая мононуклеоз. Если условия для активного размножения вирусов не благоприятны и иммунная система организма функционирует нормально, то лимфокриптовирус может оставаться невыявленным, и человек либо становится носителем вируса, либо болезнь протекает в скрытой форме, похожей на обычную простуду.
При заболевании инфекционным мононуклеозом происходят изменения в составе крови, увеличивается размер селезенки, печени и лимфоузлов (везде). Среди других симптомов отмечается лихорадка, отечность слизистой оболочки носа и глотки, покраснение миндалин, общее отравление организма – тошнота, головная боль, повышение температуры и усиление потоотделения, и так далее.
При обращении пациента в медицинское учреждение, врачи проведут дифференциальную диагностику инфекционного мононуклеоза. Специалисты будут исключать заболевания, при которых происходит воспаление и увеличение размеров миндалин, слизистых оболочек зева, печени, селезенки, слюнных желез и лимфоузлов на шее, в паху и других областях, сопровождаемые интоксикацией, сыпью и повышением температуры. Эти симптомы могут частично или полностью проявляться при ВИЧ, ЦМВ-инфекции, токсоплазмозе, вирусном гепатите, краснухе, кори, лимфогранулематозе, а также ангинах другого происхождения, дифтерии. Дифференциальный диагноз инфекционного мононуклеоза должен быть обоснован результатами анализов и комплексным обследованием у инфекциониста, отоларинголога, иммунолога, гастроэнтеролога и других специалистов.
Для подтверждения заболевания необходимо тщательно изучить состав клеток в крови. Анализ крови следует проводить натощак или не ранее, чем через 8-9 часов после еды.
Какие тесты крови нужно пройти для выявления мононуклеоза:
- исследование крови (подробный анализ гемограммы);
- анализ биохимических показателей;
- серологическое исследование;
- иммуноферментный анализ (ИФА);
- иммунохемилюминесцентный анализ (ИХЛА);
- полимеразная цепная реакция (ПЦР).
Исследователи в лаборатории изучают уровень СОЭ, содержание гемоглобина, наличие атипичных мононуклеаров и их процентное соотношение к другим видам лейкоцитов. Они также должны определить три вида антигенов, которые составляют белковую оболочку ВГЧ-4: EA (ранний), VCA (капсидный), EBNA (ядерный) эпитопы. Исследователи проводят анализ крови на наличие антител классов Ig двух типов – M и G – к вирусу.
У человека, который выздоровел после мононуклеоза, в результатах анализа крови обнаруживается нарушение состава крови в течение 6–9 месяцев, но показатели постепенно улучшаются. В этот период человек прекращает прием лекарств и должен тщательно следить за профилактикой мононуклеоза, чтобы не заразить других и предотвратить повторное заболевание. Рекомендуется проводить контрольные анализы каждые 3 месяца в течение года после выздоровления.
Показания для сдачи анализа
Проведение анализа крови на мононуклеоз у детей рекомендуется в случае наличия следующих признаков:
- Неприятные ощущения в области головы, боли в суставах и мышцах, утрата аппетита и ощущение тошноты.
- Повышенная температура тела. Температурные показатели могут колебаться от 37,5 до 40,0 градусов Цельсия. Иногда наблюдается небольшая лихорадка (от 37,1 до 37,4 градусов Цельсия). Для мононуклеоза нехарактерны симптомы, такие как озноб и усиленное потоотделение.
- Увеличение размеров лимфатических узлов. Сначала изменения затрагивают узлы, расположенные под затылком и на задней стороне шеи. По мере развития болезни поражаются подмышечные и даже паховые лимфатические узлы. Они могут быть маленькими, как горошинка, или достигать размеров грецкого ореха. Увеличение лимфатических узлов не сопровождается изменением кожи и не вызывает болезненных ощущений. Иногда возможно небольшое недомогание в этой области.
- Боль в горле у ребенка. Сопровождается увеличением миндалин. Поверхность покрыта белесым налетом, который можно легко удалить ватным тампоном.
- Появление назальности из-за увеличения миндалин.
- Легкое заложенность носа. При этом у ребенка нет выделений слизи.
- В острой фазе инфекции печень и селезенка также подвергаются изменениям.
- Болезненность в области живота при увеличении лимфатических узлов в этой зоне.
У 10-15% людей возникают разнообразные по местоположению и размерам высыпания на коже.
Общий анализ крови при мононуклеозе у детей
При проведении анализа крови у маленьких пациентов с инфекционным мононуклеозом важно обращать внимание на уровень лейкоцитов, присутствие мононуклеаров и изменения в содержании гранулоцитов. Моноциты, пораженные вирусом и подвергшиеся бластной трансформации (активному размножению клеток), называются мононуклеары. В начальной стадии заболевания эти элементы могут быть необнаружимы при общем анализе крови, их появление обычно наблюдается на 2-3 день после заражения.
Для этого заболевания нетипичны такие заболевания, как тромбоцитопения и анемия. У малой части больных наблюдается небольшое увеличение количества лейкоцитов (повышение числа кровяных клеток) или лейкопения (резкое снижение их числа). Скорость оседания эритроцитов (СОЭ) у ребенка будет незначительно изменена. Количество палочкоядерных нейтрофилов и тромбоцитов увеличится.
Если инфекционный мононуклеоз проходит без осложнений, то уровень тромбоцитов и лейкоцитов будет в норме. При других развитиях событий количество клеток снижается.
Биохимический анализ
Анализ биохимии крови также часто используется для выявления инфекций. При этом уровень альдолазы, участвующей в обмене энергии, значительно возрастает. Также часто отмечается увеличение уровня щелочной фосфатазы. Повышенные уровни прямого билирубина указывают на развитие желтухи, а увеличение непрямого билирубина может свидетельствовать о тяжелых последствиях мононуклеоза, таких как гемолитическая аутоиммунная анемия.
Моноспот
Исследование на инфекционный мононуклеоз, известное как моноспот, также является очень эффективным. Оно проводится для выявления у ребёнка гетерофильных антител в крови. Этот анализ дает результаты в 90% случаев при первичном заражении, если начальные симптомы появились не позднее чем через 2-3 месяца. Однако при хронической форме болезни у ребёнка моноспот не покажет никаких изменений.
Во время обработки крови происходит соединение с биологическим катализатором. Если происходит агглютинация – склеивание клеток, то обнаруживаются гетерофильные антитела (образующиеся при заражении). Это подтверждает диагноз «мононуклеоз» у ребёнка и исключает другие заболевания.
Лечение
Чаще всего организм самостоятельно справляется с вирусом. Специфической терапии не существует, однако рекомендуется проводить симптоматическое лечение для облегчения состояния больного.
Основное внимание в лечении уделяется укреплению организма и иммунной системы. Процедуры проводятся в амбулаторных условиях. Только пациентов с серьезной формой заболевания госпитализируют.
Обычно лечение является комплексным и включает в себя следующие медикаменты:
- Средства для снижения температуры. Для уменьшения высокой температуры обычно принимают Ибупрофен, Нурофен, Парацетамол или Панадол для детей. Необходимо снижать температуру, если она поднимается выше 38 градусов. Эти препараты не принимаются по курсам, а используются по мере необходимости. Если высокая температура длится долго, следует обратиться к врачу.
- Препараты для облегчения горла. При инфекционном мононуклеозе часто возникают боли в горле. Чтобы предотвратить осложнения в виде ангины и уменьшить неприятные симптомы, назначают препараты, такие как Тантум Верде, Стрепсилс, Фарингосепт, Гексорал с обезболивающим и противовоспалительным действием.
- Витамины. Для укрепления организма обычно назначают поливитаминные комплексы или отдельно витамины группы В и С.
- Препараты для печени. Если вирус оказывает сильное воздействие на печень, назначается специальная диета вместе с желчегонными средствами, такими как Аллохол, Хофитол, Фламин. Они стимулируют функции печени и усиливают выработку желчи.
- Антибиотики. Антибактериальная терапия назначается в случае присоединения бактериальной инфекции к вирусной. Курс приема антибиотиков может продолжаться от 3 до 10 дней. Чаще всего назначаются Амоксициллин, Ципрофлоксацин. Пенициллины не применяются, так как они оказывают более агрессивное воздействие на организм.
- Противовирусные препараты. Противовирусные препараты наиболее эффективны на ранних стадиях заболевания. Для уничтожения вируса герпеса и усиления иммунного ответа организма часто назначают Виферон, Анаферон, Эргоферон.
Важно при лечении мононуклеоза соблюдать постельный режим, избегать физических нагрузок в течение 1-2 недель, правильно питаться и употреблять больше чистой воды. После завершения лечения пациент должен посещать инфекциониста в течение полугода.
Прогноз и профилактика
Прогноз при мононуклеозе, обычно, всегда благоприятный. Это заболевание, как правило, проходит без осложнений в большинстве случаев и приводит к формированию пожизненного иммунитета. В случае тяжелого течения заболевания или отсутствия лечения мононуклеоз может перейти в хроническую форму и сопровождаться периодическими рецидивами.
У людей с ВИЧ-инфекцией инфекционный мононуклеоз может иметь неблагоприятный прогноз. Из-за ослабления иммунной системы организма болезнь может протекать в более тяжелой форме.
Для предотвращения заражения инфекционным мононуклеозом необходимо соблюдать простые правила профилактики:
- Избегание контакта с зараженным. Единственный способ заражения мононуклеозом — от человека-носителя. Если в семье есть больной, рекомендуется изолировать его от других членов семьи, предоставив отдельную комнату, посуду, полотенце, а также регулярно проветривать помещение. Использование медицинской маски поможет предотвратить заражение.
- Укрепление организма. Закаливание организма способствует укреплению иммунной системы. Полезными также являются прогулки на свежем воздухе, воздушные и солнечные ванны. Для маленьких детей вместо закаливания рекомендуется обтирание теплой или прохладной водой.
- Правильное питание. Состояние иммунитета во многом зависит от питания. Большая часть витаминов усваивается не в форме препаратов, а из пищи. Для укрепления иммунитета важно употреблять больше свежих овощей, фруктов, ягод, а также не забывать о нежирном мясе, кисломолочных продуктах и крупах.
- Соблюдение правил личной гигиены. Вирус Эпштейна-Барр может передаваться через слюну или другие жидкости организма. Для предотвращения заражения необходимо регулярно мыть руки, использовать только личное полотенце, зубную щетку, бритву и мочалку.
Не существует специфических мероприятий для предотвращения мононуклеоза. Единственным способом защитить себя от этого заболевания является сильный иммунитет и избегание контакта с зараженными людьми. Согласно исследованиям, после 35 лет у всех людей формируется иммунитет к этому заболеванию, поэтому можно не беспокоиться о возможном заражении.
Подготовка
Приготовление к анализу крови требует тех же самых правил, что и любое другое исследование. Если пациент употребляет какие-либо препараты, анализ следует проводить через 2 недели после завершения приема лекарств. В случае прерывания лечения или невозможности перенести обследование пациент должен уведомить врача, поскольку препараты могут повлиять на результаты анализа.

Перед сдачей крови рекомендуется уменьшить физическую активность за 2 дня, а в день анализа соблюдать легкую и здоровую диету. Также стоит избегать стрессов, поскольку нервозность может негативно отразиться на результатах анализа.
Для посещения лаборатории необходимо быть натощак, разрешается выпить небольшое количество воды. Перед сдачей крови рекомендуется провести около 15 минут в покое. Поэтому диагностические лаборатории начинают работу с утра. После процедуры можно позавтракать и заниматься физическими упражнениями.
Нельзя проводить процедуру сдачи крови во время активного воспалительного процесса. Это относится как к обострениям хронических заболеваний, так и к простуде или острым инфекциям. В таких случаях наблюдается значительное увеличение уровня лейкоцитов, но это не даст объективной картины, указывающей на мононуклеоз.
Рекомендуется женщинам проходить анализ после окончания менструации. В период беременности следует согласовать процедуру с гинекологом, а при планировании зачатия – выполнять анализ по его рекомендации. Для общего анализа берется кровь из пальца, а для других видов требуется венозная кровь.
Причины и признаки
Инфекционный мононуклеоз относится к заболеваниям, вызванным вирусом герпеса. Развитие мононуклеоза может быть вызвано вирусом Эпштейн-Барра (вирус герпеса 4 группы). Он передается воздушно-капельным путем и попадает в кровоток через слизистую носоглотки.
Иногда довольно сложно быстро обнаружить инфекционный мононуклеоз, поскольку диагностика затруднена отсутствием специфических маркеров. Даже после тщательного обследования это заболевание можно перепутать с другими заболеваниями.
Инфекционный мононуклеоз относится к группе заразных заболеваний. Передача возможна при поцелуе, использовании общих полотенец и столовых приборов, а также при любом незначительном контакте.
Источником заражения является только человек, у которого в настоящее время протекает острая фаза заболевания.
Признаки инфекционного мононуклеоза могут различаться в зависимости от реакции организма на вирус:
- Повышение температуры. При мононуклеозе может наблюдаться повышение температуры до 39 градусов, сопровождающееся лихорадкой, ознобом и бредом.
- Увеличение лимфатических узлов. При мононуклеозе лимфатические узлы значительно увеличиваются и становятся болезненными при ощупывании. Если человек поднимает голову вверх, подчелюстные лимфоузлы становятся заметными.
- Боль в горле. Поскольку вирус в первую очередь поражает слизистую оболочку, у больного появляются симптомы простуды: отек слизистой носа, болезненные ощущения в горле, першение, а также возможен сухой кашель.
- Головная боль. Головные боли могут быть связаны с нарушением оттока лимфы и повышением температуры тела.
- Слабость. Вирус ослабляет организм, что приводит к быстрой утомляемости, сонливости, раздражительности и повышенной потливости.
В отличие от остальных видов вирусов герпеса, вирус Эпштейна-Барр не подавляет размножение лимфоцитов, а, наоборот, стимулирует его. Инкубационный период заболевания может продолжаться от 4 до 6 недель. За это время симптомы не проявляются.
Проявлением заболевания являются боли в горле, головные и мышечные боли, а также ощущение слабости. Увеличение лимфоузлов происходит позже. Большинство симптомов сохраняется в течение 2 недель, после чего начинается выздоровление. Возобновление заболевания, как правило, не происходит, так как организм производит антитела, обеспечивающие стойкий иммунитет.
Возможные осложнения
Чаще всего заболевание проходит без негативных последствий для организма. Осложнения возникают редко, менее чем у 1% пациентов. У детей симптомы мононуклеоза могут сохраняться в течение длительного времени, до одного или двух месяцев после выздоровления, поэтому рекомендуется внимательно следить за состоянием здоровья малыша.
При серьезном протекании заболевания могут возникнуть осложнения. В течение года после перенесенного инфекционного мононуклеоза рекомендуется регулярно проходить анализ крови, чтобы контролировать ее состав.
Среди осложнений мононуклеоза возможны следующие осложнения:
- Острый средний отит. Иногда инфекция распространяется на ткани внутреннего или среднего уха. При сильном ослаблении иммунитета может возникнуть бактериальное воспаление. Это сопровождается болями в ухе, выделениями гноя. После выхода гноя состояние стабилизируется, а температура тела снижается.
- Гайморит. Вирус Эпштейна-Барр в первую очередь атакует носоглотку, горло и дыхательные пути, что может привести к воспалению придаточных носовых пазух. Гайморит сопровождается болями в области лба, переносицы, щек, а также обильными выделениями из носа (с гнойными примесями).
- Воспаление миндалин. При мононуклеозе может возникнуть воспаление небных миндалин. Поскольку миндалины состоят из лимфоидной ткани, то при мононуклеозе они обычно увеличиваются в размере. В запущенной форме заболевания воспаление миндалин становится хроническим.
- Поражение печени. Вирус Эпштейна-Барр часто влияет на печень и селезенку. У детей с мононуклеозом может появиться желтуха. Необходимо правильно подбирать лечение, чтобы избежать серьезных осложнений с печенью.
- Гемолитическая анемия. При этом виде анемии количество эритроцитов остается прежним, но они быстро разрушаются, что приводит к кислородному голоданию тканей.
У некоторых людей также отмечались судороги, изменения в поведении и нестабильное эмоциональное состояние. Самым редким и опасным осложнением мононуклеоза является разрыв селезенки, который требует немедленной хирургической коррекции.
Почему так важно сдать этот анализ
Вирус Эпштайна-Барр может длительное время находиться в организме, не проявляя себя. Однако он не исчезает полностью, и заразившийся человек остаётся его носителем на протяжении всей жизни. Передача происходит через воздушно-капельный путь, но вирус не живёт долго во внешней среде. Риск заражения возрастает у тех, кто проживает вместе с носителем инфекции и использует его посуду.
В большинстве ситуаций вирусоносительство не представляет опасности. Риск возникает, когда иммунитет пациента ослаблен, например, из-за переохлаждения, сильного стресса или обострения хронического заболевания. В таких случаях проявляются симптомы мононуклеоза. Активное поражение лимфоидной ткани, в свою очередь, снижает иммунитет и способствует более частым и тяжелым проявлениям других заболеваний.
Ещё одна причина пройти анализ – планирование беременности. Вирус легко проникает через плацентарный барьер и нарушает развитие иммунной системы у ребёнка. Поэтому женщине, которая готовится стать матерью, необходимо пройти обследование на мононуклеоз, и если у неё обнаружен вирус Эпштайна-Барр, вылечить болезнь до зачатия. То же касается и отца ребёнка: вирус не присутствует в сперме, но существует риск заражения матери и малыша воздушно-капельным путём от больного отца.
Существует возможность жить с вирусом Эпштайна-Барр, не уступая в качестве жизни. Однако пациентам необходимо более внимательно следить за своим здоровьем, чтобы избежать обострений и предотвратить появление других инфекций. Своевременное обнаружение инфекций поможет своевременно принять необходимые меры и избежать серьезных последствий.
Как распознать недуг
При заболевании температура поднимается до 40 градусов, увеличиваются лимфатические узлы, также возникают сильные боли в горле. Эти признаки могут быть перепутаны с лихорадкой, однако, если среди сопутствующих симптомов имеются боли в суставах, головные боли, мышечные боли, воспаление миндалин и затруднение дыхания, можно предположить наличие вируса. Болезнь сопровождается отечностью шеи, с увеличением диаметров позвонков до 3 см.
При развитии патологического процесса возникает воспаление лимфатического потока брыжейки, что приводит к образованию на коже красных пятен, пигментных пятен и папул. Красные пятна на лице сохраняются до 5 дней, после чего исчезают.
Основные признаки клинического проявления заболевания включают в себя:
- Непокойный сон;
- Рвотные проявления;
- Несварение;
- Дискомфорт в центральной части живота.
Появление опухолей в области за брюшиной и увеличение лимфоузлов также могут свидетельствовать о наличии инфекции. Эти симптомы часто наблюдаются у детей с ослабленной иммунной системой.
Основные симптомы
Клинические проявления мононуклеоза у детей могут иметь различные особенности и проявляться по-разному.
Заражение инфекционным мононуклеозом происходит постепенно. Несмотря на то, что у этого заболевания существует множество симптомов и проявлений, в начальной стадии оно протекает бессимптомно. К сожалению, данное заболевание характеризуется длительным течением, и в некоторых случаях лечение может занимать до полутора лет. Инкубационный период инфекции составляет от 2 дней до 3 месяцев, но обычно длится от 2 до 3 недель.
Признаки клинического проявления заболевания:
- Отравление организма — сильное повышение температуры тела, слабость, усталость.
- Высокая температура тела.
- Значительное увеличение размеров лимфатических узлов.
- Увеличение печени — гепатомегалия.
- Увеличение размеров селезенки — спленомегалия.
- Воспаление горла.
- Кожные проявления, такие как экзема и различные высыпания.
- Воспаление миндалин — аденоидит.
- Изменения в составе крови — происходят значительные изменения в гематологии.
Первые симптомы этого заболевания могут быть похожи на грипп: в течение первых пяти дней человек чувствует сильную усталость, головные боли и вялость. На шестой день может начаться повышение температуры, которое может продолжаться несколько недель. У взрослых температура обычно сильно повышается, в то время как дети переносят это состояние немного легче. Иногда у детей температура тела во время болезни вообще не меняется.
Основным признаком заболевания является интенсивная боль в области горла. При осмотре полости рта можно заметить увеличенные миндалины, что свидетельствует о развитии отека неба и задней части языка. Это приводит к затруднениям с дыханием и заложенностью носа.
При данном заболевании происходит увеличение не только миндалин, но и лимфатических узлов. Характерной чертой этой инфекции является то, что она затрагивает все органы.
Исследование на антитела
Детектирование специфических антител позволяет выявить наличие вируса Эпштейна-Барра, оценить активность вируса и предположить срок выздоровления. В случае прогрессирования мононуклеоза в крови обнаруживаются иммуноглобулины IgM, в то время как на этапе выздоровления можно выявить IgG.
Выявление инфекции Эпштейна-Барр – сложный процесс, который не должен опираться только на один или два анализа, взятых один раз. На разных этапах заболевания показатели могут отличаться, поскольку вирус проходит через несколько фаз развития. Диагноз устанавливается на основании всех результатов исследований, проведенных в разные периоды инфекции.
Диагностика
Для успешного лечения инфекционного мононуклеоза необходимо своевременно провести его диагностику. Это потребует очень тщательного обследования, включающего развернутые анализы мочи, крови, биохимические исследования и многие другие процедуры. Эти исследования назначаются при первых признаках заболевания: увеличении лимфоузлов, лихорадке, быстрой утомляемости. Также могут потребоваться другие методы диагностики.
Клинические анализы
Для разграничения данного заболевания от других с похожими симптомами, такими как лимфолейкоз, лимфогранулематоз, стрептококковый тонзиллит и другие, необходимо провести обследование пациента на мононуклеоз. Проведение анализов крови инвитро позволяет не только точно поставить диагноз, но и оценить степень тяжести заболевания и его продолжительность.
Крови и мочи
Проведение полного анализа крови на мононуклеоз в первую очередь показывает небольшое увеличение уровня лейкоцитов, наличие мононуклеаров и также агранулоцитоз.
Мононуклеарные клетки представляют собой лимфоциты, которые подверглись воздействию вируса. Если их уровень составляет приблизительно 12%, это свидетельствует о наличии инфекции в организме.
Тем не менее, мононуклеарные клетки не всегда присутствуют в крови.
В начале заболевания отсутствуют такие клетки, их появление отмечается спустя 2-3 недели после первичного заражения. При наличии интоксикационного синдрома уровень эритроцитов может увеличиться из-за повышенной вязкости крови.
При диагностике мононуклеоза результаты общего анализа крови показывают следующие характеристики:
- уровень палочкоядерных нейтрофилов превышает 6%;
- количество лейкоцитов находится в пределах нормы или незначительно увеличено;
- скорость оседания эритроцитов превышает 22 мм/ч;
- доля лимфоцитов составляет не менее 40%;
- процентное содержание моноцитов превышает 10%;
- количество атипичных мононуклеаров превышает 10-12%.
Важно помнить, что изменения в показателях крови происходят только в случае первичной инфекции. При хронической форме заболевания практически отсутствуют изменения.
Мононуклеоз также может вызвать изменения в моче. Анализы могут показать наличие белка, билирубина, возможно небольшое количество крови и даже гной. Увеличенные уровни этих веществ объясняются нарушением функций селезенки и печени.
Инструкция по дешифрации общего анализа крови доступна в нашем видеоролике:
Биохимический
Для более точного определения состояния здоровья необходимо пройти анализ крови на биохимические показатели. В данном случае необходимо взять венозную кровь для проведения анализа. В результате могут быть обнаружены следующие отклонения от обычных значений в большую сторону:
- активность фермента альдолазы увеличивается в 2-3 раза;
- уровень фосфатазы повышается;
- концентрация билирубина в крови;
- уровень АСТ и АЛТ.
Если результаты анализа показывают повышенный уровень непрямого билирубина, это может указывать на наличие серьезного заболевания, такого как аутоиммунная анемия.
Моноспот
Данный тест агглютинации предназначен для выявления гетерофильных антител в сыворотке крови путем склеивания клеток и их осаждения. При первичном заболевании точность результатов теста составляет более 90%.
Если симптомы мононуклеоза проявились более 3 месяцев назад, тестирование не выполняется, так как считается неэффективным. Результаты анализа доступны всего через 5 минут после взятия образца крови, что значительно упрощает установку диагноза.
Также можно выполнить тест на реакцию Пауля-Буннеля. В этом случае положительная агглютинация происходит уже через 14 дней после заражения. Иногда может потребоваться повторное проведение теста. При хроническом протекании заболевания показатели не дают достоверной информации.
На вирус Эпштейна-Барра
Этот анализ позволяет определить количество антител к вирусу в организме. При заражении организм начинает производить специальные иммуноглобулины, количество которых указывает на серьезность заболевания, его продолжительность и время заражения.
В случае острой фазы инфекции в крови происходит производство иммуноглобулинов IgM, которые достигают пика через три недели после заражения. Позже появляются IgG (через 4-5 недель), их уровень в острой фазе инфекции остается высоким. В случае хронического течения количество этих антител снижается, но они остаются в крови на протяжении всей жизни.
ВИЧ
Люди, у которых есть подозрения на наличие мононуклеоза, должны обязательно сдать три раза анализ крови, чтобы определить наличие вируса ВИЧ. При этом заболевании также могут быть обнаружены моноциты в крови.
Не нужно беспокоиться, если результат анализа на ВИЧ оказался положительным. При мононуклеозе возможно ложноположительное тестирование, потому что организм начинает производить антитела, которые похожи на те, что обнаруживаются при ВИЧ. Поэтому рекомендуется провести три раза анализ крови на ВИЧ.
Исследование крови
Характер протекания мононуклеоза обычно имеет волновой характер: периоды ремиссии могут чередоваться с обострением. Из-за этого симптомы заболевания проявляются разнообразно. Для выявления инфекции необходимо сдать анализ крови не только из пальца, но и из вены.
Если не выполнить это исследование, врач может ошибочно определить диагноз и прописать антибиотики. Однако возбудитель инфекции Эпштейна-Барра не реагирует на эти препараты и требует совершенно другого подхода к лечению.
Проведение анализа крови на мононуклеоз позволит обнаружить изменения в ее составе.
Общий анализ
На ранних этапах заболевания не всегда возможно обнаружить мононуклеары: обычно атипичные клетки проявляются через 14-21 день после заражения. При длительном отравлении возможно увеличение числа эритроцитов из-за высокой вязкости крови, при этом снижение уровня гемоглобина для этого заболевания не характерно.
Изучение общей ситуации позволит обнаружить следующие изменения показателей у взрослых:
- небольшой прирост уровня СОЭ – 20-30 мм/ч;
- незначительное увеличение числа лейкоцитов и лимфоцитов;
- атипичные мононуклеары – 10-12%.
Индивидуальное состояние иммунитета оказывает влияние на эти показатели. Кроме того, время, прошедшее с момента инфицирования, играет роль. Уровень компонентов крови может оставаться нормальным при скрытой форме заболевания, однако при первичном заражении проявляются ярко выраженные изменения.
Также, в период ремиссии уровень лимфоцитов, моноцитов и нейтрофилов может быть в пределах нормы.
Необычные мононуклеары могут оставаться в крови даже через полтора года после полного выздоровления.
В случае немудреной формы заболевания также может наблюдаться нормальное количество тромбоцитов и эритроцитов, но при возникновении осложнений эти показатели могут снизиться.
При мононуклеозе у детей обычно можно обнаружить следующие отклонения в общем анализе крови:
- увеличение уровня моноцитов и лимфоцитов. При анализе результата врач должен обратить внимание на содержание моноцитов – их количество может увеличиться до 10;
- повышение числа нейтрофильных гранулоцитов;
- рост количества лейкоцитов – лейкоцитоз;
- увеличение скорости оседания эритроцитов (СОЭ);
- уровень тромбоцитов и эритроцитов. При отсутствии осложнений показатели будут в норме, при тяжелой форме болезни возможно их уменьшение;
- наличие мононуклеаров.
Обычно нет обнаружения необычных клеток в норме. Однако у детей их количество может достигать до 1%. Обычно при наличии вирусных инфекций и опухолей их количество может быть 10% и более.
Когда уровень мононуклеарами достигает 10%, это является надежным признаком наличия мононуклеоза.
Сколько раз сдают кровь
Для пациента с мононуклеозом необходимо регулярно сдавать анализ крови, поскольку на различных этапах инфекции уровень определенных показателей может меняться. Обычно при первичном обследовании в начальной стадии атипичные мононуклеары не обнаруживаются.
Также, в процессе лечения врачу может понадобиться оценить изменения в состоянии пациента и выявить возможные осложнения.
Повторный медицинский осмотр может показать, как происходит процесс выздоровления. Это особенно важно после того, как человек перенес острую форму болезни.
Проведение исследований требует трех этапов. Первый и второй этапы анализа проходят с интервалом в 3 месяца, а завершающий этап – через 3 года. Такая практика поможет исключить возможное наличие ВИЧ-инфекции.
Как правильно сдавать анализ
Для достижения точных результатов важно соблюдать следующие рекомендации:
- для проведения диагностики необходимо быть натощак;
- перед прохождением обследования нужно воздержаться от еды как минимум в течение 8 часов до посещения медицинского учреждения;
- пить воду следует в ограниченном количестве или вообще отказаться от нее;
- за 14 дней до проведения исследования необходимо прекратить принимать любые лекарственные препараты;
- за 24 часа до обследования следует избегать жирной пищи и алкоголя;
- за двое суток до диагностики желательно снизить физическую активность и вести спокойный образ жизни.
Кроме этого, перед проведением диагностических процедур не рекомендуется слишком нервничать, чтобы избежать искажения результатов.
Частые вопросы
Какие анализы обычно проводят для проверки на инфекционный мононуклеоз?
Для проверки на инфекционный мононуклеоз обычно проводят анализы крови, такие как общий анализ крови, анализ на антитела к вирусу Эпштейна-Барр и анализ на наличие вируса в крови.
Каковы симптомы инфекционного мононуклеоза?
Симптомы инфекционного мононуклеоза могут включать усталость, боль в горле, увеличение лимфоузлов, лихорадку, увеличение селезенки и печени, а также высыпания на коже.
Полезные советы
СОВЕТ №1
Обратитесь к врачу для проведения специального анализа крови на наличие антител к вирусу Эпштейна-Барр. Это позволит точно определить наличие инфекционного мононуклеоза.
СОВЕТ №2
Следуйте рекомендациям врача относительно подготовки к анализу, включая возможное ограничение приема пищи и жидкости перед взятием крови.